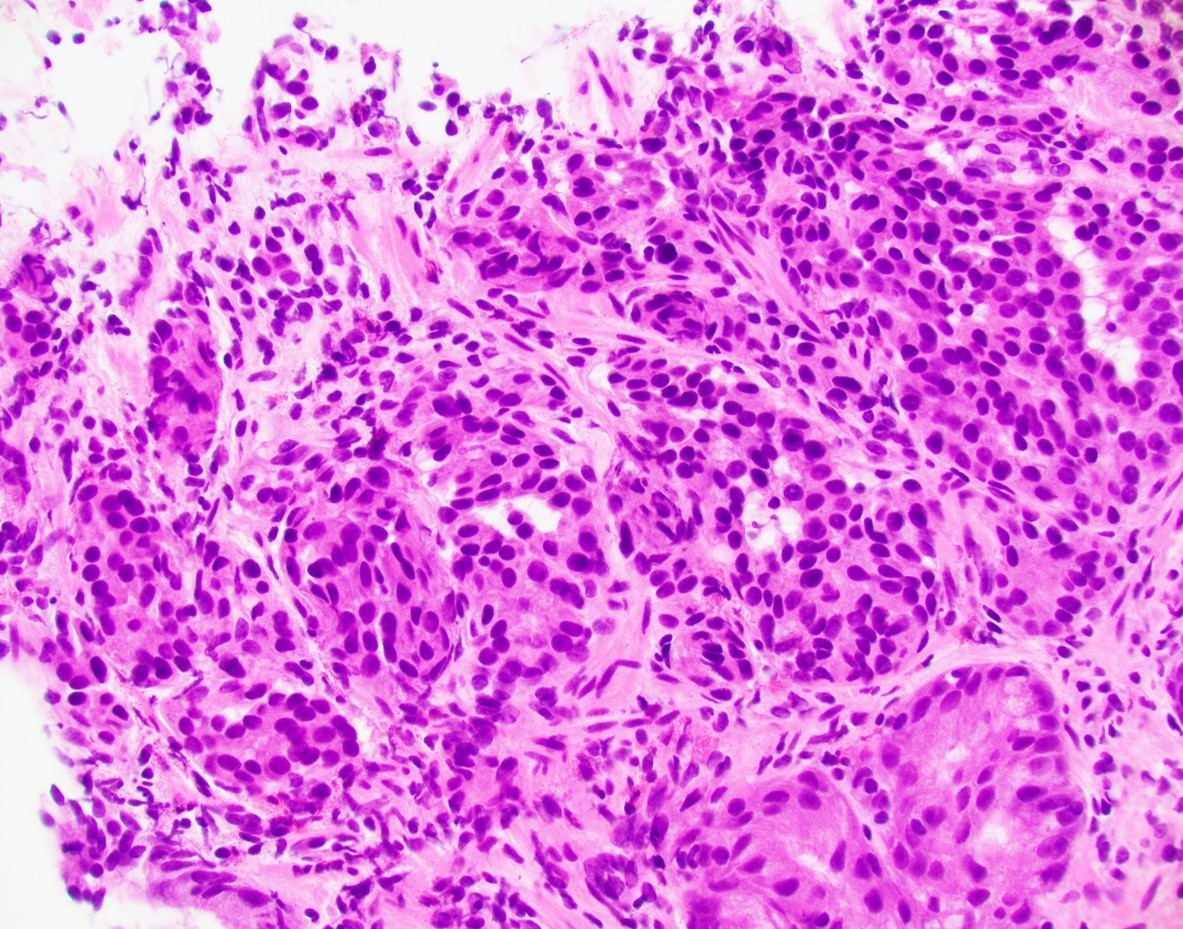
Picture1

Case History
A 56-year-old female underwent upper endoscopy for dyspepsia. A 1 cm gastric nodule was found and biopsied. The histological findings are shown in Figure1 (low power) and Figure 2 (high power). Synaptophysin immunostaining of the tumor (Figure 3) and the background mucosa (Figure 4) are included.
What is the diagnosis?
- NET, type 1
- NET, type 2
- NET, type 3
- NET, cannot be classified

Answer: A: Type 1 Gastric NET
This NET is occurring in a background of atrophic oxyntic mucosa, also known as autoimmune metaplastic atrophic gastritis ( AMAG), which typically shows nodular neuroendocrine cell hyperplasia (ECL) highlighted by synaptophysin stain ( Figure 4}. Intestinal metaplasia is also seen in Figure 1. Psedopyloric metaplasia (another characteristic) feature cannot be appreciated in the provided photographs. Even though Gastrin stain is not provided, the staining pattern of neuroendocrine cells is not that of G cells. Type 1 gastric NETs are typically small, multiple, low grade, associated with antibodies for intrinsic factor/ parietal cell, often have iron deficiency or B12 deficiency, and are managed by endoscopic surveillance. Type 3 NETs are sporadic, not associated with atrophic corpus gastritis. Type 2 are rare, can show ECL hyperplasia, but are associated with MEN1/gastrinoma and parietal cell hyperplasia.
Case contributed by: Deepti Dhall, M.D., Professor and Associate Director, Anatomic Pathology; GI Section Head